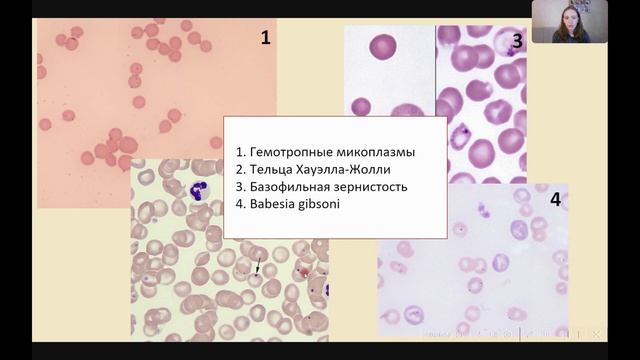
Упоротый Подкаст - Ксения Таскина: гемоплазмы, гемобартонеллы и бартонеллы.

ВетНам 34 Наталья Колядина 03.06.2024.

Расскажите об этом видео своим друзьям в социальных сетях!
QR-код страницы с видео

Видео ВетНам 34 Наталья Колядина 03.06.2024.
Гость программы: Наталья Колядина ветеринарный врач-репродуктолог ЛДВЦ МВА андролог неонатолог врач ультразвуковой диагностики к.в.н. Тема эфира: Ветеринарная репродуктология Побеседуем: - научная деятельность в ветеринарии - наука и пра..., видео от 2024-08-20 загрузил на rutube Упоротый Ветеринар...